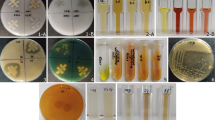

Abstract
Few studies have evaluated endophytic bacteria in relation to plant growth promotion, nitrogen uptake and biological control. The aim of this study was to molecularly and physiologically characterize thirteen endophytic bacteria strains, evaluate their biological control properties and their ability to promote plant growth and plant N nutrition. All the strains produced indole acetic acid and promoted increase of plant biomass, N accumulative amount and N-use efficiency index. None of the strains carries the nifH gene. Four strains stimulated plant nitrate reductase activity, four solubilized phosphate, nine produced siderophores and none produced HCN. Seven strains inhibited Bipolaris sacchari growth and one was antagonistic to Ceratocystis paradoxa. The pathogens were inhibited by the production of diffusible and volatile metabolites by the bacterial strains. Moreover, this is the first study to demonstrate the effect of Delftia acidovorans on sugarcane plant growth, nitrogen metabolism improvement and antagonism to B. sacchari. The most efficient strains in promoting plant growth and exhibiting antagonistic activities towards fungal pathogens were Herbaspirillum frinsingense (IAC-BECa-152) and three Pantoea dispersa strains (IAC-BECa-128, IAC-BECa-129, and IAC-BECa-132). These bacteria show potential to be used as inoculants for sustainable agricultural management, mainly at the seedling production phase.
Similar content being viewed by others
Explore related subjects
Discover the latest articles, news and stories from top researchers in related subjects.Avoid common mistakes on your manuscript.
Introduction
Beneficial microorganisms that inhabit the soil and influence plant development are known as plant growth-promoting bacteria and their effects have been studied worldwide (Finkel et al. 2018). The endophytic bacteria that colonize and live in internal plant tissue have also been extensively explored in different plants (Hardoim et al. 2015; Kumar et al. 2017). These microorganisms promote plant growth through different mechanisms, such as biological nitrogen fixation (BNF), increase of nitrate reductase activity, production and release of plant hormones (auxins; indole acetic acid, gibberellins and cytokinins), phosphate solubilization, suppression of pathogens through siderophore production, synthesis of antibiotic, induction of systemic resistance, production of diffusible and volatile organic compounds, such as hydrocyanic acid (Olanrewaju et al. 2017) and others. Endophytic bacteria are also able to produce enzymes, such as ACC (1-aminocyclopropane-1-carboxylate) deaminase, that can promote plant growth by lowering plant ethylene levels (Rashid et al. 2012; Glick 2014). Thus, the use of plant growth-promoting endophytes is of great interest to enhance plant growth and protect plant from pathogens (Kruasuawan and Tramchaipen 2016).
In the last few decades, studies with diazotrophic bacteria, from the classical diazotroph Acetobacter, obtained from sugarcane (Cavalcante and Döbereiner 1988), to the endophytic Achromobacter insolitus, able to improve growth and N metabolism of wheat plants (Silveira et al. 2016), have intensified due to their potential as agents of growth promotion and plant protection (Marques et al. 2008). Several studies demonstrated the positive effect of endophytic bacteria on plants of economic interest, such as banana (Patel et al. 2017), maize (Alves et al. 2015), tomato (Upreti and Thomas 2015), groundnut (Dhole et al. 2016) and others. In sugarcane crop, the Acetobacter (Dong et al. 1995), Pantoea (Quecine et al. 2012) and Gluconacetobacter (James et al. 2001) bacteria promote beneficial effects on plant growth due to BNF, indole acetic acid (IAA) production and others mechanisms. Studies have shown that plant genetic factors contribute to increase plant growth efficiency with such microorganisms and that establishment of an endophyte in the plant can cause plant physiological changes that modulate plant growth and development (Conrath et al. 2006; Carvalho et al. 2006).
Brazil is the world’s largest sugarcane producer, and the management of this crop has changed due to the expansion of sugarcane culture in the country. One of the management strategies is the use of commercial inoculants, composed of bacteria strains, such as endophytic bacteria that can stimulate the plant growth (Oliveira et al. 2006; Pandey et al. 2017). Seedlings production, one of main stages of cropping system, is conducted in nurseries via micropropagation and mini-stalks using organic substrates, which can favour the beneficial bacteria inoculation. It is known that endophytic microorganisms community that inhabit sugarcane tissues is more diverse than previously thought (Souza et al. 2016). It can make bacterial strains introduction more difficult due to higher space and niches competition. It may justify the importance to search for different and more efficient bacterial plant-promoting strains.
Endophytic bacterial strains can benefit sugarcane from the seedlings stage until field cropping. Sugarcane production can dramatically be reduced by pathogens, such as Ceratocystis paradoxa and Bipolaris sacchari (Girard and Rott 2000; Bournival et al. 1994). Finding endophytes with antagonist properties against these pathogens would be of great interest (Fávaro et al. 2012). In this aspect, strains with multiple characteristics in regard to plant growth promotion and biological control properties are still limited.
Despite the finding that there is a great diversity of bacteria that endophytically inhabit sugarcane tissues (Souza et al. 2016), there are few studies that have evaluated endophytic bacteria in relation to plant growth promotion, nitrogen uptake and biological control. In addition, the search for new bacterial strains that meet the inoculants market is constant, since it is known that strains can lose their efficacy (Meena et al. 2017), requiring their substitution. The inoculant market is growing worldwide, especially in Brazil, and bacteria, mainly endophytic with multiple beneficial characteristics, such as growth promotion and antagonism to pathogens, should be prioritized for use in inoculant formulations.
In this study sugarcane endophytes were evaluated for their ability to promote plant growth and improve plant N nutrition. Bacterial endophytes were characterized molecularly (16S rRNA gene sequencing and the presence of nifH) and physiologically (inorganic phosphate solubilization; siderophore, IAA, antifungal hydrocyanic acid and, diffusible and volatile organic compounds production). We hypothesized that endophytic bacteria trigger beneficial changes on sugarcane nitrogen metabolism which turns in plant growth promotion.
Materials and methods
All strains were obtained from the Agronomic Institute (Instituto Agronômico—IAC—Campinas, São Paulo, Brazil) Culture Collection, isolated from healthy stems and roots of sugarcane cultivated under field cropping. Based on a previous screening for sugarcane seedling growth-promotion (Freitas 2011), thirteen endophytic bacteria strains were selected from 162 strains.
This study was divided into two parts. In part one, we performed a greenhouse experiment to evaluate the effects of endophytic bacteria on sugarcane seedlings in regard to plant nitrogen concentration, accumulation and use-efficiency index, and plant nitrate reductase activity. In part two, we characterized the strains by nifH gene presence, sequencing the 16S rRNA gene, and evaluated the strains for beneficial bacterial traits.
Part 1: greenhouse experiment and nitrogen analysis
The strains were evaluated on micropropagated sugarcane plants in a greenhouse experiment. The plantlets were obtained from the apical meristem of the variety IACSP95-5000 and cultivated in vitro (Sreenivasan and Sreenivasan 1984) for 70 days and then transferred to 50 mL flasks containing 15 mL of Murashige and Skoog (MS) medium (Murashige and Skoog 1962). Nitrogen and other salts were used at a tenth of the recommended concentration, and no growth hormones were added to the MS medium. The clumps of micropropagated sugarcane were divided into four and transferred to flasks with MS medium using the same composition.
We prepared each bacterial inoculum by cultivating the strains on dextrose, yeast, glutamate (DYGS—Döbereiner et al. 1995) medium for 7 days at 30 °C. The inoculum density was adjusted to 108 colony-forming units (CFU) mL−1. The plantlets were inoculated with 0.1 mL of bacterial suspension and placed in a growth chamber at 75% humidity, 14 h light of 60 m2 lx intensity and 10 h of darkness at 27 °C for 7 days. After this period, the plantlets were transferred to pots containing 500 mL of sterilized commercial substrate (Carolina Soil®—composed by sphagnum peat, expanded vermiculite, dolomitic limestone and agricultural gypsum) and held in a greenhouse. The plantlets were covered with a plastic screen to reduce the light incidence by 60%. During the first month, only sterile water was used for irrigation; thereafter, a low-N nutrient solution (2 mL of solution A and 3 mL of solution B per liter; solution A: 200 g calcium nitrate, 250 g calcium chloride and 20 g ConMicrosStandart®perliter; solution B: 200 g potassium nitrate, 150 g monopotassium phosphate, 300 g magnesium sulphate and 100 g potassium chloride per liter) was added to the pots. After 2 months, a new division of clumps was performed, and the plants were transferred to 1 L pots containing sterilized commercial substrate (Carolina Soil®) and reinoculated (2 mL) with the strains. During the first month, only sterile water was used for irrigation, and during the subsequent months, a low-N nutrient solution was used. After 2 months, the plastic screen was removed. After 4 months, leaf samples were collected to determine nitrate reductase activity and, subsequently, the plants were harvested. The other plants were dried at 60 °C to determine root and shoot dry matter (five replicates per treatment). The shoot dry matter was ground and homogenized to determine the nitrogen concentration by micro-Kjeldahl method (Bremner 1965), the cumulative amount of N and the efficiency index of N utilization (Siddiqi and Glass 1981).
The nitrate reductase activity was determined by placing 200 mg of plant tissue discs in 5 mL of buffered substrate (200 mM KNO3 in 50 mM phosphate buffer, pH 7.5) containing 0.5% Tween-20, according to Reed et al. (1980). The activity was measured by the absorbance at 540 nm.
Part 2: strains characterization
Phosphate solubilization ability
The phosphate solubilization ability of the strains was first analyzed by a qualitative test using a procedure that evaluates the solubilization of inorganic phosphate (CaHPO4) on solid medium (Katznelson and Bose 1959). The strains that developed a clear halo surrounding the colonies were considered to be phosphate solubilizers. The level of solubilization was quantified in liquid medium containing 5 g CaHPO4 L−1 as the only source of phosphorus (Murphy and Riley 1962; Nautiyal 1999). The amount of dissolved phosphorus was measured by atomic emission plasma spectrometry. The level of solubilization was also related to the total protein content.
Total protein determination
Total protein of the strain suspensions was determined using the method of Lowry et al. (1951) and modified by Rodrigues (2004). To 0.1 mL of the sample, 0.4 mL of sterile distilled H2O and 0.5 mL of 1 M NaOH were added. The suspension was shaken and placed in a water bath for 5 min at 100 °C to lyse the cells; then, after the samples had reached room temperature, 0.25 mL of Lowry reagent was added to the sample, which was incubated for 10 min in the dark. Subsequently, 0.5 mL of Folin–Ciocalteau reagent (2:1 dilution of the reagent in distilled H2O) was added, and the sample was shaken; then, the suspension was again incubated in the dark for 30 min. After this, the absorbance was measured at 750 nm. Protein concentration was calculated based on a standard curve prepared using Bovine Serum Albumin (BSA).
Indole acetic acid (IAA) quantification
IAA production was quantified according to Kojima (1996) adapted for microbial cultures. The strains were grown in 250 mL of DYGS medium containing 100 mg l-tryptophan L−1 and incubated for 72 h under constant stirring in the dark at 30 °C. The sample was centrifuged at 14,000 × g for 15 min at 4 °C. The supernatant was filtered through a 0.22 µm Millipore filter, and a 5 mL aliquot was acidified using 1 N HCL to pH 2.5 and partitioned three times with diethyl ether using a separating funnel. The extract was evaporated and suspended in 300 µL of methanol. The samples were analyzed by high-performance liquid chromatography (HPLC) using a C18 reversed-phase column. The results were expressed in µg IAA per mg total protein.
Siderophore production
Siderophore production was measured using the method of Schwyn and Neilands (1987), in which the dye is released from a dye-iron complex when a ligand sequesters the iron complex; this reaction causes a color change from blue to yellow-orange. The dye used was chromeazurol S (CAS), and the binder was one or more of the siderophores found in the culture supernatants of the bacterial strains.
Hydrocyanic acid production (HCN)
The capacity of HCN production by the strains was evaluated according to Bakker and Schippers (1987). The strains were grown on PDA medium supplemented with 4.4 g L−1 of glycine to stimulate the production of hydrocyanic acid. A filter paper impregnated with 0.5% picric acid and 2% Na2CO3 was laid on a cover plate, which was then sealed with Parafilm and incubated at 28 °C. Color change of the paper from yellow to orange indicated the production of hydrocyanic acid by the strain.
Antifungal activity assay by paired culture (PC), volatile organic compound (VOC) and diffusible compound (DC) tests
The antagonistic properties of the strains were evaluated for two pathogenic fungi, B. sacchari and C. paradoxa, using the paired culture (PC) method. The fungi were cultured in Petri dishes containing potato dextrose agar (PDA) medium for 7 days (C. paradoxa) and 10 days (B. sacchari). For the PC tests, the bacterial strains (grown in DYGS liquid medium for 4 days) were arranged as streaks on one side of the Petri dish with PDA medium; a 5 mm PDA culture medium containing the pathogen mycelial disc was placed on the opposite side. The control treatment contained only the mycelial disc of the pathogen. Antagonistic action was determined by the formation of a zone of inhibition (halo without mycelial growth). Strains that inhibited pathogen growth were tested for the production of volatile organic compounds (VOCs) and diffusible compounds (DC). To analyze the VOCs, the technique of overlapping plates proposed by Dick and Hutchinson (1966) was used. A disc of pathogen culture was placed at the center of a Petri dish containing PDA, and 0.1 mL of the antagonist was inoculated on another plate. The Petri dishes containing the pathogen was superimposed over the plate containing the antagonist, and both were wrapped in plastic film and incubated at 28 °C. The production of DC was analyzed using the cellophane method (Gibbs 1967); the antagonist culture was grown in DYGS liquid medium, and the Petri dish containing PDA medium was covered with sterile cellophane overlaid with a sterile filter paper disc. In the center of each plate, 0.1 mL of the antagonist was inoculated on the surface of the filter paper. After 5 days, the filter paper and the cellophane with the colony of antagonists were removed, and a disc of PDA containing the pathogen was transferred to the center of the plate. Both tests were evaluated after total medium coverage by the mycelium of the pathogen in the control treatment by measuring the pathogen mycelial growth. The tests were performed using five replicates per treatment, which included a control treatment containing only the pathogen.
Amplification of the nifH gene
Genomic DNA was extracted using the Wizard Genomic DNA Purification Kit (Promega) according to the manufacturer’s instructions. The presence of the nifH gene was determined using the polymerase chain reaction (PCR) and the nifH forward and reverse primers Polf (TGC-GAY-CCS-AAR-GCB-GAC-TC) and Polr (ATS-GCC-ATC-ATY-TCP-CCG-GA), and PPf (GCA-AGT-CCA-CCA-CCT-CC) and PPr (TCG-CGT-GGA-CCT-TGT-TG), as described by Ueda et al. (1995). The PCR method was as follow: denaturation at 94 °C for 4 min., followed by 35 cycles (94 °C for 1 min, 50 °C for 45 s and 72 °C for 2 min), with a final extension at 72 °C for 4 min. The amplification products were electrophoresed on a 1.5% agarose gel in 1xTAE buffer.
16S rRNA gene amplification and sequencing
Bacterial genomic DNA was extracted using the Wizard Genomic DNA Purification Kit (Promega) according to the manufacturer’s instructions. We amplified the 16S rRNA gene from all the strains using the primers 27f (AGAGTTTGATCCTGGCTCAG) and 1492r (GGTTACCTTGTTACGACTT) with the PCR conditions as follows: 94 °C for 2 min, followed by 30 cycles of 94 °C for 1 min, 55 °C for 1 min and 72 °C for 3 min, with a final extension at 72 °C for 10 min. The amplification products were electrophoresed on a 1.0% agarose gel in 1xTE buffer, purified using the QIAquick Gel Extraction Kit (QIAGEN), cloned into the pGEM T-plasmid (pGEM-T Easy Kit, Promega) and transformed into JM109 Escherichia coli competent cells according to the manufacturer’s instructions. For each amplified and transformed fragment, eight single colonies were sequenced using the BigDye Terminator v3.1 Kit and an automated DNA capillary sequencer (ABI PRISM 3700 DNA Analyser, PE Applied Biosystems, HITACHI); the primers used were T7 (TAATACGACTCACTATAGGG) and SP6 (ATTTAGGTGACACTATAGAA). For each fragment, all 16S rRNA gene partial sequences obtained were assembled into a contig using the Phred/Phrap/CONSED program (repeat stringency 0.5) (Ewing et al.1998; Gordon et al. 1998). The sequences were identified by comparing the contiguous 16S rRNA gene sequences obtained with 16S rRNA sequence data from the references and type strains available in the GenBank and RDP (Ribosomal Database Project, Wisconsin, USA) data bases using BLASTn and the RDP classifier, respectively. The phylogenetic tree was obtained by aligning (ClustalW) nearly full-length 16S rRNA gene sequences and reference sequences and using the neighbour-joining method (Saitou and Nei 1987); bootstrapping values were based on 1000 repetitions.
Statistical analysis
The results were subjected to analysis of variance, and the means were tested using the Scott–Knott test at 5% (P < 0.05).
Results
Part 1: greenhouse experiment with sugarcane plantlets
All the strains contributed to increase dry matter compared with the non-inoculated control treatment. Except for IAC-BECa-105, all strains improved shoot dry mass, and seven of them improved root dry mass (Table 1). Four strains (IAC-BECa-023, IAC-BECa-126, IAC-BECa-129, IAC-BECa-152) promoted an increase in shoot N increase in shoot N concentration and twelve strains increased shoot N cumulative amount. Plants inoculated with all strains, excepted strain IAC-BECa-023, showed higher values of efficiency index of N utilization than the control plant. The activity of nitrate reductase in leaves was significantly higher in plants inoculated with four different strains (IAC-BECa-026, IAC-BECa-152, IAC-BECa-101 and IAC-BECa-105) than in the control plants (Table 1).
Part 2: strains characterization
All 13 strains produced IAA at levels between 0.04 and 5.37 µg of IAA per mg of protein (Table 2). Four strains (IAC-BECa-128, 129, 132 and 162) exhibited the ability to solubilize phosphate by qualitative and quantitative tests, and nine strains (IAC-BECa-023, 026, 126, 128, 129, 132, 152, 102 and 105) produced siderophores. None of the strains produced HCN. The nifH sequence did not be amplified using the Pol primers in any of the thirteen strains, but positive detection of nifH was verified for the positive controls (data not shown).
Seven strains (IAC-BECa-023, 128, 129, 132, 098, 101, 102) that showed an inhibition zone of B. sacchari mycelium growth in the test of the PC also acted as antagonists for DC and VOC tests (Table 3). For the pathogen C. paradoxa, only the strain IAC-BECa-129 inhibited mycelial growth for all antifungal tests.
The 16S rRNA gene sequences of 13 strains were compared with the 16S rRNA of phylogenetically closely related bacteria (Fig. 1). The strains were clustered into seven different groups. IAC-BECa-105 is in the cluster of Methylobacterium species and IAC-BECa-023 is in the Delftia species cluster. IAC-BECa-152 is similar to Herbaspirillum frisingense, while IAC-BECa-046 is similar to Burkholderia caribensis. Strain IAC-BECa-162 clusters with different species of Burkholderia; IAC-BECa-098 was placed in the Pseudomonas species cluster; and IAC-BECa-026, IC-BECa-128, IAC-BECa-132 and IAC-BECa-129 were clustered with Pantoea. The strains IAC-BECa-102, IAC-BECa-101 and IAC-BEC-126 were in the Enterobacter cluster. The final sequences of the studied strains are available in GenBank (under the accession numbers in Table 2).
Discussion
Some of the sugarcane endophytic strains characterized in this study have already been described as plant growth-promoting bacteria. The strains IAC-BECa-152, similar to H. frisingense, and IAC-BECa-046, to B. caribensis, which have beneficial characteristics related plant growth (Kirhhof et al. 2001; Marcos et al. 2016, Schlemper et al. 2018), improved, respectively, 45 and 37% of the total dry mass (TDM) according the relative efficiency (Table 4). The other strains were clustered in different groups of Methylobacterium and Enterobacter cloacae. The strains were also clustered with genera already known as endophytes of sugarcane, such as Burkholderia, Pseudomonas and Pantoea (Mendes et al. 2007; Shahid et al. 2017). The strain IAC-BECa-023, identified as Delftia acidovorans, a species which includes some strains that already have been described as plant growth-promoting bacteria of soybean and pea plants (Adesemoye et al. 2017) and also been isolated from endophytic tissues of sugarcane (Mehnaz et al. 2010). However, this is the first study to show the growth promotion effect of D. acidovorans on sugarcane seedling, with an improvement of 34% of the TDM.
Recently, endophytes have been tested in sugarcane in a mixed inoculum, which increased the plant nitrate reductase activity (Marcos et al. 2016), an effect related to an increase in nitrate uptake, mainly under low N concentrations (Donato et al. 2004). The inoculation of IAC-BECa-152, 105, 026 101 strains in micropropagated sugarcane resulted in higher plant nitrate reductase activity up to 137, 103, 130 and 90% (Table 4).
BNF is attributed to endophytic bacteria as a benefit to host plant development; however, it is known that N fixation is not the only benefit triggered by these microorganisms (Vacheron et al. 2013). In the present study, the selected strains, despite exhibiting potential as plant-growth promoters, did not fix N based on the absence of nifH gene amplification. Sevilla et al. (2001), while studying a nifH mutant of G. diazotrophicus PAL5 in sugarcane, verified that the plant growth stimulus might be associated with auxin production. The production of auxin is related to plant growth stimulation and the proliferation of secondary roots (Patten and Glick 2002). Microbe-plant associations may have a large influence on this production, especially during the early stages of development and rooting (Kröber et al. 2014). Microorganisms produce growth-promoting substances, including indole compounds that possess rings, such as auxins. IAA is the most active auxin and has been widely studied due to its role in promoting both fast responses, such as increased cell elongation, and slow responses, such as cell division and differentiation (Bailly et al. 2014; Cherif-Silini et al. 2016). The strains studied here are IAA producers, which may have contributed to plant growth. The ability to synthesize phytohormones, including IAA, is widely distributed amongst plant-associated bacteria (Duca et al. 2014), showing that the bacteria can trigger this effect in different plants such as leguminous vegetables (Ahmed et al. 2014), rice (Pittol et al. 2016), lettuce (Cipriano et al. 2016), sugarcane (Rampazzo et al. 2018), chrysanthemum (Cipriano and Freitas 2018) and other crops.
In addition to the ability to produce phytohormones, nine strains produced siderophores, substances that may increase iron availability to the plant and inhibit the growth of pathogenic microorganisms (Compant et al. 2005). Four strains were able to solubilize phosphate, which is well described as plant growth-promoting trait in several host plants (Bonaldi et al. 2015; Kielak et al. 2016), including strains isolated from sugarcane (Xing et al. 2016), and thus, may have contributed to sugarcane-growth promotion.
Endophytic bacteria with antagonistic activities towards soil-borne fungal pathogens have already been reported (Vurukonda et al. 2018). Moreover, biological control by endophytes is evident in several crops, such as olives (Cabanás et al. 2014), tomato cultivars (Upreti and Thomas 2015) and rice (Verma et al. 2018). In sugarcane, P. dispersa is endophytically associated with this host plant and representatives of this genus can detoxify albicidins (a family of phytotoxins) produced by Xanthomonas albilineans, that causes sugarcane leaf scald disease (Zhang and Birch 1997; Ding and Melcher 2016). The plant growth-promoting bacteria of the genus Delftia also exhibited broad-spectrum antifungal activity to different pathogens such as Fusarium, Colletotrichum, Rhizoctonia and Pythium (Prasannakumar et al. 2015), but our data are the first to show activity against B. saccharis through volatiles compounds production. The inhibition of pathogens can occur through various mechanisms, including competition for nutrients, production of volatile organic compounds (VOCs) and non-volatile substances, competition for colonization sites and induction of systemic resistance (Eljounaidi et al. 2016; Khalaf and Raizada 2018). Selecting strains that inhibit the growth of more than one pathogen may provide support for the use of endophytes in disease suppression and plant-growth promotion. Several bacteria such as Pseudomonas, Bacillus and Burkholderia are antagonistic towards Bipolaris (Rafikova et al. 2016; Bach et al. 2016) and Ceratocystis species (Zhang et al. 2014). However, to date, there are no studies showing antagonism between endophytic bacteria and sugarcane pathogens such as C. paradoxa and B. sacchari. In the present study, we selected for the first time the endophytic bacterium P. dispersa (IAC-BECa-129) able to inhibit the mycelial growth of B. sacchari and C. paradoxa due to direct antagonism triggered by diffusible compound and VOC production (Table 3). Although the strains studied here do not produce HCN, a typical VOC, these strains were able to inhibit pathogen mycelial growth due to diffusible compounds and probably by producing other VOCs, not determined in this study, such as dimethyl sulphide and pyrazine (Hernández-León et al. 2015; Rybakova et al. 2016). As far as we know the strains D. acidovorans (IAC-BECa-023) and P. dispersa (IAC-BECa128, 129 and 132) are the first able to produce VOCs, besides diffusible compounds, revealing an opportunity to investigate the role of the selected strains in B. sacchari control.
All thirteen strains promoted up to 66% increases in shoot dry matter, 54% in root dry matter and 68% in N accumulation. This growth promotion, as well as the increase in N nutrition (as reflected by the N concentration, N cumulative amount, N utilization efficiency index and nitrate reductase activity), might be related to improved nutritional efficiency resulting from more efficient plant-bacteria interaction. Higher nutritional efficiency due to associations with microorganisms could be related to plant growth and improved nutrient absorption (Mantelin and Touraine 2004; Barretti et al. 2008). Indeed our results support that hypothesis since the plants with higher nutritional efficiency also obtained the higher values for biomass.
Endophytic bacteria that exhibit plant growth promotion and biological control features have the potential to be used as inoculants, potentially replacing — completely or partially — chemical fertilizers and pesticides. In addition, this technology is less expensive than chemical application and has a low environmental impact, allowing sustainable agricultural management. In this study, we add to knowledge about the interaction between endophytes and sugarcane, including antagonism tests related to important sugarcane diseases. The bacteria H. frinsingense (IAC-BECa-152), three P. dispersa strains (IAC-BECa-128, IAC-BECa-129, IAC-BECa-132) and D. acidovorans (IAC-BECa-023) exhibited the best results in regard to plant growth, production of compounds such as siderophore and IAA, ability to solubilize phosphate, VOC production and direct antagonism to B. sacchari and C. paradoxa.
Many studies, previously, reported the effects of endophytes on sugarcane and other crops regarding to strains characterization and antagonism to several pathogen. Although these studies have already shown the beneficial effect of Burkholderia, Enterobacter, Herbaspirillum, Pantoea and Methylobaterium in several cultures, this is the first study to show that the endophytic bacteria Delftia dispersa (strain IAC-BECa-023) is responsible for the growth of sugarcane seedlings and N metabolism improvement. Further studies with the present strains under field conditions will elucidate their impact on sugarcane and pathogen interactions. In summary, we broaden the knowledge of the growth-promoting bacteria, including the antagonistic potential triggered by volatile substances of endophytes strains to the pathogens B. sacchari and C. paradoxa.
References
Adesemoye AO, Yuen G, Watts DB (2017) Microbial inoculants for optimized plant nutrient use in integrated pest and input management systems. In: Kumar V, Kumar M, Sharma S, Prasad R (eds) Probiotics and plant health. Springer, Singapore
Ahmed I, Ehsan M, Sin Y, Paek J, Khalid N, Hayat R, Chang YH (2014) Sphingobacterium pakistanensis sp. nov., a novel plant growth promoting rhizobacteria isolated from rhizosphere of Vigna mungo. A van Leeuw 105:325–333. https://doi.org/10.1007/s10482-013-0077-0
Alves GC, Videira SS, Urquiaga S, Reis VM (2015) Differential plant growth promotion and nitrogen fixation in two genotypes of maize by several Herbaspirillum inoculants. Plant Soil 387:307–321. https://doi.org/10.1007/s11104-014-2295
Bach E, Seger GDS, Fernandes GC et al (2016) Evaluation of biological control and rhizosphere competence of plant growth promoting bacteria. Appl Soil Ecol 99:141–149. https://doi.org/10.1016/j.apsoil.2015.11.002
Bailly A, Groenhagen U, Schulz S, Geisler M, Eberl M, Weisskopf L (2014) The inter-kingdom volatile signal indole promotes rootdevelopment by interfering with auxin signaling. Plant J 80:758–771. https://doi.org/10.1111/tpj.12666
Bakker AW, Schippers B (1987) Microbial cyanide production in the rhizosphere in relation to potato yield reduction and Pseudomonas spp.: mediated plant growth-stimulation. Soil Biol Biochem 19:451–457
Barretti PB, Souza RM, Pozza EA (2008) Bactérias endofíticas como agentes promotores do crescimento de plantas de tomateiro e de inibição in vitro de Ralstonia solanacearum. Ciênc Agrotec 32:731–739
Bonaldi M, Chen X, Kumova A, Pizzatti C, Saracchi M, Cortesi P (2015) Colonization of lettuce rhizosphere and roots by tagged Streptomyces. Front Microbiol. https://doi.org/10.3389/fmicb.2015.00025
Bournival BL, Ginoza HS, Schenck S, Moore PH (1994) Characterization of sugarcane response to Bipolaris sacchari: inoculations and host-specific HS-toxin. Phytopathology 84:672–676
Bremner JM (1965) Total nitrogen. In: Black CA (ed) Methods of soil analysis. American Society of Agronomy, Madison, pp 1149–1178
Cabanás CGL, SchiliròE V-CA, Mercado-Blanco J (2014) The biocontrol endophytic bacterium Pseudomonas fluorescens PICF7 induces systemic defense responses in aerial tissues upon colonization of olive roots. Front Microbiol. https://doi.org/10.3389/fmicb.2014.00427
Carvalho AV, Alves BJR, Reis VM (2006) Resposta do dendezeiro à adição de nitrogênio e sua influência na população de bactérias diazotróficas. Pesq Agrop Brasileira 41:293–300
Cavalcante VS, Döbereiner J (1988) A new acid tolerant nitrogen-fixing bacteria associated with sugarcane. Plant Soil 10:823–831
Cherif-Silini H, Silini A, Yahiaoui H, Ouzari I, Boudabous A (2016) A phylogenetic and plant-growth-promoting characteristics of Bacillus isolated from the wheat rhizosphere. Ann Microbiol 66:1087–1097. https://doi.org/10.1007/s13213-016-1194
Cipriano MAP, Freitas SS (2018) Effect of Pseudomonas putida on chrysanthemum growth under greenhouse and field conditions. Afr J Agric Res 13:302–310
Cipriano MAP, Lupatini M, Lopes-Santos L et al (2016) Lettuce and rhizosphere microbiome responses to growth promoting Pseudomonas species under field conditions. FEMS Microbiol Ecol. https://doi.org/10.1093/femsec/fiw197
Compant S, Duffy B, Nowak J, Clement C, Barka EA (2005) Use of plant growth-promoting bacteria for biocontrol of plant diseases: principles, mechanisms of action, and future prospects. Appl Environ Microbiol 71:4951–4959
Conrath U, Beckers GJ, Flors V, García-Agustín P, Jakab G, Mauch F, Newman MA, Pieterse CM, Poinssot B, Pozo MJ et al (2006) Priming: getting ready for battle. Mol Plant Microbe Interact 19:1062–1071
Dhole A, Shelat H, Vyas R, Jhala Y, Bhange M (2016) Endophytic occupation of legume root nodules by nifH-positive non-rhizobial bacteria, and their efficacy in the groundnut (Arachshypogaea). Ann Microbiol 66:1397
Dick CM, Hutchinson SA (1966) Biological activity of volatile fungal metabolites. Nature 211:868
Ding T, Melcher U (2016) Influences of plant species, season and location on leaf endophytic bacterial communities of non-cultivated plants. PLoS ONE 11(3):0150895. https://doi.org/10.1371/journal.pone.0150895
Döbereiner J, Baldani VLD, Baldani JI (1995) Como isolar e identificar bactérias diazotróficas de plantas não-leguminosas. Embrapa-SPI, Brasília, p p60
Donato VMTS, Andrade AG, Douza ES, França JGE, Maciel GA (2004) Atividade enzimática em variedades de cana-de-açúcar cultivadas in vitro sob diferentes níveis de nitrogênio. PesqAgrop Bras 39:1087–1093
Dong Z, Heydrich M, Bernard K, McCully ME (1995) Further evidence that the N2-fixing endophytic bacterium from theintercellular spaces of sugarcane stems is Acetobacter diazotrophicus. Appl Environ Microbiol 61(5):1843–1846
Duca D, Lorv J, Patten C, Rose D, Glick B (2014) Microbial indole-3-acetic acid and plant growth. Anton Van Leeuwenhoek 106:85–125
Eljounaidi K, Lee SY, Bae H (2016) Bacterial endophytes as potential biocontrol agents of vascular wilt diseases: review and future prospects. Biol Control 103:62–68. https://doi.org/10.1016/j.biocontrol.2016.07.013
Ewing B, Hillier L, Wendl MC, Green P (1998) Base-calling of automated sequencer traces using Phred. I. Accuracy assessment. Genom Res 8:175–185
Fávaro LCL, Sebastianes FLDS, Araújo WL (2012) Epicoccum nigrum P16, a sugarcane endophyte, produces antifungal compounds and induces root growth. PLoS ONE 7(6):e36826. https://doi.org/10.1371/journal.pone.0036826
Finkel OM, Castrillo G, Paredes SH, Gonzaléz IS, Dangl JL (2018) Understanding and exploiting plant beneficial microbes. Curr Opin Plant Biol 38:155–163
Freitas RP (2011) Bactérias diazotróficas endofíticas associadas à cana-de-açúcar. Dissertation, Instituto Agronômico de Campinas
Gibbs JN (1967) A study of the epiphytic growth habit of Fomes annosus. Ann Bot 32:755–774
Girard JC, Rott P (2000) Pineaple disease. In: Rott P, Bailey RA, Comstock JC, Croft BJ, Saumtally AS (eds) A guide to sugarcane diseases. CIRAD-ISSCT, Montpellier, pp 131–135
Glick BR (2014) Bacteria with ACC deaminase can promote plant growth and help to feed the world. Microbiol Res 169:30–39
Gordon D, Abajian C, Green P (1998) Consed: a graphical tool for sequence finishing. Genom Res 8:195–202
Hardoim PR, van Overbeek LS, Berg G, Pirttilä CS, Campisano A, Dörin M, Sessitch A (2015) The gidden world within plants: ecological and evolutionary considerations for defining functioning of microbial endophytes. Microbiol Mol Biol Rev 79:293–320
Hernández-León R, Rojas-Solís D, Contreras-Pérez M, Orozco-Mosqueda MC, Macías-Rodríguez LI, Cruz HR, Valencia-Cantero E, Santoyo G (2015) Characterization of the antifungal and plant growth-promoting effects of diffusible and volatile organic compounds produced by Pseudomonas fluorescens strains. Biol Control 81:83–92. https://doi.org/10.1016/j.biocontrol.2014.11.011
James Ek, Olivares FL, de Oliveira AL, dos Reis FB Jr., da Silva LG, Reis VM (2001) Further observations on the interaction between sugar cane and Gluconacetobacter diazotrophicus under laboratory and greenhouse conditions. J Exp Bot 52:747–760
Katznelson H, Bose B (1959) Metabolic activity and phosphate dissolving capability of bacterial isolates from wheat roots, rhizosphere, and non rhizosphere soil. Can J Microb 5:79–85
Khalaf EM, Raizada MN (2018) Bacterial seed endophytes of domesticated cucurbits antagonize fungal and oomycete pathogens including powdery mildew. Front Microbiol 9:42
Kielak AM, Cipriano MAP, Kuramae EE (2016) Acidobacteria strains from subdivision 1 act as plant growth-promoting bacteria. Arch Microbiol. https://doi.org/10.1007/s00203-016-1260-2
Kirhhof G, Eckert B, Stoffels M, Baldani JI, Veronica MR, Hartmann A (2001) Herbaspirillum frisingense sp. nov., a new nitrogen-fixing bacterial species that occurs in C4-fibre plants. Int J Syst Evol Microbiol 51:157–168
Kojima K (1996) Changes of absicic acid, indole-3-acetic acid and gibberellin-like substances in flowers and developing fruits of citrus cultivar Hyaganatsu. Sci Hortic 65:901–902
Kröber M, Wibberg D, Grosch R (2014) Effect of the strain Bacillus amyloliquefaciensFZB42 on the microbial community in the rhizosphere of lettuce under field conditions analyzed by whole metagenome sequencing. Front Microbiol 5:252. https://doi.org/10.3389/fmicb.2014.00252
Kruasuwan W, Thamchaipenet A (2016) Diversity of culturable plant growth-promoting bacterial endophytes associated with sugarcane roots and their effect of growth by co-inoculation of diazotrophs and actinomycetes. J Plant Growth Regul. https://doi.org/10.1007/s00344-016-9604-3
Kumar M, Grader G, Sessitsch A, Mäki A, van Elsas JD, Nissien R (2017) Plants assemble species specific bacterial communities from common core taxa in three arcto-alpine climate zones. Front Microbiol. https://doi.org/10.3389/fmicb.2017.00012
Lowry OH, Rosenbrough NJ, Farr AL, Randal RJ (1951) Protein measurement with the Folin Phenol Reagent. J Biol Chem 193:265–275
Mantelin S, Touraine B (2004) Plant growth-promoting bacteria and nitrate availability: impacts on root development and nitrate uptake. J Exp Bot 55:27–34
Marcos FCC, Iório RPF, Silveira APD, Ribeiro RV, Machado EC, Lagôa AMA (2016) Endophytic bacteria affect sugarcane physiology without changing plant growth. Bragantia 75:1–9. https://doi.org/10.1590/1678-4499.256
Marques JRRBM, Canellas LP, Silva LGO (2008) Promoção de enraizamento de microtoletes de cana-de-açúcar pelo uso conjunto de substâncias húmicas e de bactérias diazotróficas endofíticas. Rev Bras Ciência Solo 32:1121–1128
Meena VS, Meena SK, Verma JP, Kumar A, Aeron A, Mishra PK, Bisht JK, Pattanayak A, Naveed M, Dotaniya ML (2017) Plant beneficial rhizospheric microorganism (PBRM) strategies to improve nutrients use efficiency: a review. Ecol Eng 107:8–32
Mehnaz S, Baig DN, Lazarovits G (2010) Genetic and phenotypic diversity of plant growth promoting rhizobacteria isolated from sugarcane plants growing in Pakistan. J Microbiol Biotechnol 20:1614–1623
Mendes R, Pizzinari-Kleiner AA, Araujo WL, Raaijmakers JM (2007) Diversity of cultivated endophytic bacteria from sugarcane: genetic and biochemical characterization of Burkholderia cepacia complex isolates. Appl Environ Microbiol. https://doi.org/10.1128/AEM.01222-07
Murashige T, Skogg FA (1962) Revised medium for rapid growth and bioassays with tobacco tissue cultures. Physiol Plant 15:397–473
Murphy J, Riley JP (1962) A modified single solution method for determination of phosphate in natural waters. Anal Chem Acta 27:31–36
Nautiyal CS (1999) An efficient microbiological growth medium for screening phosphate solubilizing microorganisms. FEMS Microbiol Lett 170:265–270
Olanrewaju O, Glick BR, Babalola OO (2017) Mechanisms of action of plant growth promoting bacteria. World J Microbiol Biotechnol. https://doi.org/10.1007/s11274-017-2364-9
Oliveira AL, Canuto EL, Urquiaga AL, Reis AL, Baldani JI (2006) Yield of micropropagated sugarcane varieties in different soil types following inoculation with diazotrophic bacteria. Plant Soil 284:23–32
Pandey PK, Mayanglambam CS, Sungh S, Sing AK, Kumar M, Pathak M, Shakywar BC, Pandey AK (2017) Inside the plants: endophytic bacteria and their functional attributes for plant growth promotion. Int J Curr Microbiol Appl Sci 6:11–21
Patel DH, Naik JH, Amaresan N (2017) Synergistic effect of root-associated bacteria on plant growth and certain physiological parameters of banana plant (Musa acuminate). Arch Agron Soil Sci. https://doi.org/10.1080/03650340.2017.1410703
Patten CL, Glick BR (2002) Role of Pseudomonas putida indoleacetic acid in development of the host plant root system. Appl Environ Microbiol 68:3795–3801. https://doi.org/10.1128/aem.68.8.3795-3801
Pittol M, Durso L, Valiati VH, Fiuza LM (2016) Agronomic and environmental aspects of diazotrophic bacteria in rice fields. Ann Microbiol 66:511–527
Prasannakumar SP, Gowtham HG, Hariprasad P (2015) Delftia tsuruhatensis WGR-UOM-BT1, a novel rhizobacterium woth PGPR properties from Rauwolfia serpentina (L.) Benth. Ex Kurz supressess fungal phytopathogens by producing a new antibiotic-AMTM. Lett Appl Microbiol 61:460–468
Quecine MC, Araújo WL, Rossetto PB, Ferreira A, Tsui S, Lacava PT, Mondin M, Azevedo JL, Pizzirani-Kleinera AA (2012) Sugarcane growth promotion by the endophytic bacterium Pantoea agglomerans 33.1. Appl Environ Microbiol 78:7511–7518
Rafikova GF, Korshunova TY, Minnebaev LF, Chetverikov SP, Loginov ON (2016) A new bacterial strain, Pseudomonas koreensis IB-4, as a promising agent for plant pathogen biological control. Microbiology 85:333–341
Rampazzo PE, Marcos FCC, Cipriano MAP, Marchiori PER, Freitas SS, Machado EC, Nascimento LC, Brocchi M, Ribeiro RV (2018) Rhizobacteria improve sugarcane growth and photosynthesis under well-watered conditions. Ann Appl Biol 172:309
Rashid S, Charles TC, Glick BR (2012) Isolation and characterization of new plant growth-promoting bacterial endophytes. Appl Soil Ecol 61:217–224
Reed AJ, Below FE, Hageman RH (1980) Grain protein accumulation and the relationship between leaf nitrate reductase and proteases activities during grain development in maize. Plant Physiol 66:1179–1183
Rodrigues EP (2004) Caraterização fisiológica de estirpes de Azospirillum amazonense e a avaliação dos efeitos da inoculação em plantas de arroz inundado. Federal Rural of Rio de Janeiro, Seropédica, Rio de Janeiro
Rybakova D, Cernava T, Köberl M, Liebminger S, Etemadi M, Berg G (2016) Endophytes-assisted biocontrol: novel insights in ecology and the mode of action of Paenibacillus. Plant Soil 405:125–140. https://doi.org/10.1007/s11104-015-2526-1
Saitou N, Nei M (1987) The neighbor-joining method: a new method for reconstructing phylogenetic trees. Mol Biol Evol 4:406–425
Schlemper TR, Dimitrov MR, Silva FAO, van Veen JA, Silveira APD, Kuramae EE (2018) Effect of Burkholderia tropica and Herbaspirillum frisingense strains on sorgun growth isplant genotype dependent. Peer J 6:e5346. https://doi.org/10.7717/peerj.5346
Schwyn B, Neilands JB (1987) Universal assay for the detection and determination of siderophores. Ann Biochem 160:47–56
Sevilla M, Burris RH, Gunapala N, Kennedy C (2001) Comparison of benefit to sugarcane plant growth and 15N2 incorporation following inoculation of sterile plants with Acetobacter diazotrophicus wild type and Nif− mutant strains. Mol Plant Microbe Interact 14:358–366
Shahid I, Rzwan M, Baig DN, Saleem RS, Malik KA, Mehnaz S (2017) Secondary metabolites production and plant growth promotion by Pseudomonas chlororaphis and P. aurantiaca strains isolated from cactus, cotton, and para grass. J Microbiol Biotechnol 27:480–491
Siddiqi MY, Glass ADM (1981) Utilization index: a modified approach to the estimation and comparison of nutrient efficiency in plants. J Plant Nutr 4:289–302
Silveira APD, Sala VMR, Cardoso EJBN, Labanca EG, Cipriano MAP (2016) Nitrogen metabolism and growth of wheat plant under diazotrophic endophytic bacteria inoculation. Appl Soil Ecol. https://doi.org/10.1016/j.apsoil.2016.07.005
Souza RSC et al (2016) Unlocking the bacterial and fungal communities assemblages of sugarcane microbiome. Sci Rep 6:28774. https://doi.org/10.1038/srep28774
Sreenivasan J, Sreenivasan TV (1984) In vitro propagation of Sccharum officinarum L. x Sclerostachya fusca (Roxb) a cane hybrid. Theor Appl Genet 67:171–174
Ueda T, Suga Y, Yahiro N, Matsuguchi T (1995) Remarkable N2-fixing bacterial diversity detected in Rice roots by molecular evolutionary analysis of nifH gene sequences. J Bacteriol 177:1414–1417
Upreti R, Thomas P (2015) Root-associated bacterial endophytes from Ralstonia solanacearum resistant and susceptible tomato cultivars and their pathogen antagonistic effects. Front Microbiol 6:255. https://doi.org/10.3389/fmicb.2015.00255
Vacheron J, Desbrosses G, Bouffaud M-L, Touraine B, Moënne-Loccoz Y, Muller D, Legendre L, Wisniewski-Dyé F, Prigent-Combaret C (2013) Plant growth- promoting rhizobacteria and root system functioning. Front Plant Sci. https://doi.org/10.3389/fpls.2013.00356
Verma SK, Kingsley K, Bergen M, English C, Elmore M, Kharwar RN, White JF (2018) Bacterial endophytes from rice cut grass (Leersiaoryzoides L.) increase growth, promot root gravitropic response, stimulate root hair formation, and protect rice seedlings from disease. Plant Soil 422:223–238
Vurukonda SSKP, Giovanardi D, Stefani E (2018) Plant growth promoting and biocontrol activity of Streptomyces spp. as endophytes. Int J Mol Sci 19:952
Xing YX, Wei CY, Mo Y, Yang LT, Huang SL, Li YR (2016) Nitrogen-fixing and plant growth-promoting ability of two endophytic bacterial strains isolated from sugarcane stalks. Sugar Tech 18:373–379. https://doi.org/10.1007/s12355-015-0397-7
Zhang L, Birch RG (1997) Mechanisms of biocontrol by Pantoea dispersa of sugar cane leaf scald disease caused by Xanthomonas albilineans. J Appl Microbiol 82:448–454. https://doi.org/10.1046/j.1365-2672.1997.00135.x
Zhang XH, Zhao GH, Li DW, Li SP, Hong Q (2014) Identification and evaluation of strain B37 of Bacillus subtilis antagonistic to Sapstain fungi on poplar wood. Sci World J. https://doi.org/10.1155/2014/149342
Acknowledgements
The authors acknowledge FAPESP financial support and CAPES for Master and Post-doctoral fellowships. This research was supported by BIOEN/FAPESP (2008/56147-1), The Netherlands Organization for Scientific Research (NWO-729.004.013), and the CNPq/NWO Program (Project Number 456420/2013-4).
Author information
Authors and Affiliations
Contributions
APDS conceived the study. APDS, RPFI, FCCM, AOF, SCS and MAPC performed the experiments. APDS, RPFI, EEK and MAPC wrote the paper.
Corresponding author
Ethics declarations
Conflict of interest
The authors declare that they have no conflict of interest.
Rights and permissions
About this article
Cite this article
da Silveira, A.P.D., Iório, R.P.F., Marcos, F.C.C. et al. Exploitation of new endophytic bacteria and their ability to promote sugarcane growth and nitrogen nutrition. Antonie van Leeuwenhoek 112, 283–295 (2019). https://doi.org/10.1007/s10482-018-1157-y
Received:
Accepted:
Published:
Issue Date:
DOI: https://doi.org/10.1007/s10482-018-1157-y